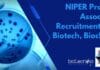
NIPER Project Associate Recruitment For Biotech, Biochem – Applications Invited NIPER Project Associate Recruitment

JNCASR – Project Oriented Biology Education (POBE) Program – 2018
JNCASR - Project Oriented Biology Education (POBE) Program - 2018
This job expires in :
An amazing opportunity for 1st year BSc students in any stream...
Projects/Dissertation, PG Diploma & Certification Programmes for your career enhancement : Application Invited
Projects/Dissertation, PG Diploma & Certification Programmes for your placement & career enhancement: Application Invited
Institute of Good Manufacturing Practices India, registered as a non-profit society...
Openings for Medical Writer @ Docplexus, Pune
Docplexus is looking for a seasoned Medical Writer. This role is responsible for creating medical content from scratch. We are the largest and fastest...
Notification For CRP-ICGEB Research Grant / Early Career Return Grants – 2017
ICGEB Research Grants - 2017
CRP Collaborative Research Program
Purpose & Subject Areas
The ICGEB Research Grant is part of the Collaborative Research Programme (CRP) of ICGEB...
Biogenuix Medsystems Pvt. Ltd Hiring For -Technical Sales / Sr. Sales Executive Post
Biogenuix Medsystems is national private firm whose existence has been in the Biotech market for last 10 years. Differentiating through quality products & top...
SERB Indo-US Postdoctoral Research Fellowship For Indian Researchers : 2016-17
SERB Indo-US Postdoctoral Research Fellowship (2016-17) call announced
Online Application Submission Deadline: 28 Feb 2017
Science and Engineering Research Board (SERB; www.serb.gov.in) in partnership with the...
SFARI Explorer Awards | Get Fund of $70,000 For Research in Autism Spectrum Disorders...
Simons Foundation Autism Research Initiative (SFARI) Explorer Awards
SFARI mission
The mission of the Simons Foundation Autism Research Initiative (SFARI) is to improve the understanding, diagnosis and...
Women Scientists in Life Sciences Apply For Training Program on Proteomics Approaches By DST,...
Training Program on
Proteomics Approaches for
Women Scientists in Life Sciences
Sponsored by : Department of Science & Technology (DST), Government of India New Delhi
Organized by : Department of...
JRF Position in NMPB Project @ Manipal University, Jaipur
Applications are invited for the position of JRF to work in the NMPB, New Delhi Funded Research Project entitled “Ex- situ Conservation Using In...
The 18th Indo-US Flow Cytometry Workshop | CSIR-Central Drug Research Institute, Lucknow
The 18th Indo-US Flow Cytometry Workshop
“Applications of Flow Cytometry in Drug Development and Research” International Society for the Advancement of Cytometry
CSIR-Central Drug Research...
Research Scientist With Rs 55,000/- pm @ JNU, School of Life Sciences – Delhi
School of Life Sciences
Jawaharlal Nehru University
New Delhi 110067
Positions available
Applications were invited from for the following posts in an industry sponsored project. The project entitled...
Exclusive Job Opportunity for Life Science Candidates | Work as Consultant @ International AIDS...
The International AIDS Vaccine Initiative (IAVI) is a global, not-for-profit, public-private product development partnership organization whose mission is to ensure development of safe, effective...
Thomson Reuters Hiring Associates in Biotech Patent Research | Apply Online
Thomson Reuters provides professionals with the intelligence, technology and human expertise they need to find trusted answers.We enable professionals in the financial and risk,...
Subject Matter Specialist (Plant Protection) Post Vacant with Rs 44,500/- pm Salary @ SSM
Sanskriti Samvardhan Mandal (SSM) has been active in integrated rural development since 1959. Started with a small school, SSM has now grown into a...
Laboratory Auxillary Trainee Post Vacant @ CMC – Vellore, Dept of Transfusion Medicine &...
Christian Medical College and Hospital, Vellore is a private, minority-run educational and research institute that includes a network of primary, secondary and tertiary care...